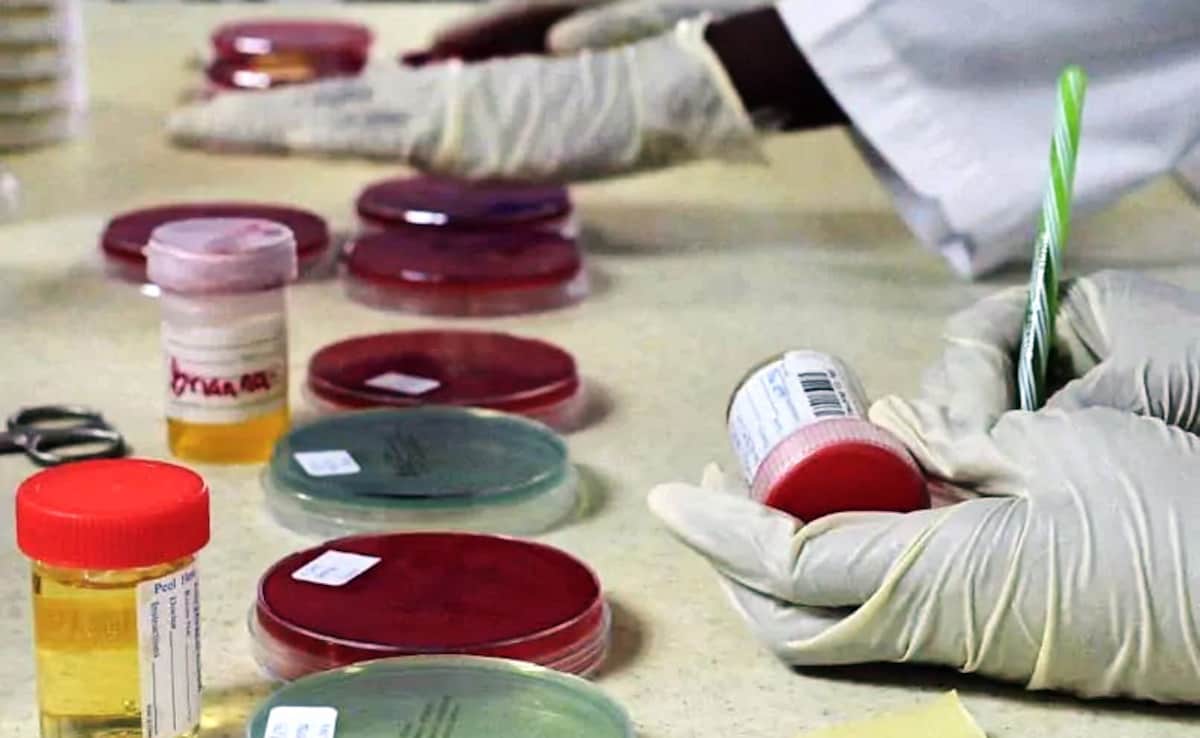

India Tops Global Doping List For Third Year. Ministry Says Progress Amid 2036 Olympic Bid
India topped the list for a third consecutive year, something that might hurt its chances when the International Olympic Committee (IOC) evaluates its bid to host the 2036 Olympic Games in the near future.
- PTI
- Updated: December 19, 2025 05:26 pm IST
India's shambolic doping record is being addressed aggressively and a marginal decline in the overall positivity rate in the recently-released 2024 international testing figures is evidence that awareness campaigns are making a difference as the country bids to host the 2036 Olympics, a Sports Ministry source asserted on Friday. As per the latest testing figures released by WADA (World Anti-Doping Agency), India conducted 7113 tests (6576 urine samples and 537 blood samples) last year. Of these, 260 returned adverse analytical findings, accounting for a positivity rate of 3.6 per cent, the highest among all major countries which conducted 5,000 or more tests.
India thus topped the list for a third consecutive year, something that might hurt its chances when the International Olympic Committee (IOC) evaluates its bid to host the 2036 Olympic Games in the near future.
Asked if the Sports Ministry is concerned about the impact of this doping record on the ambitious Olympic bid, a top source pointed to the marginal decline compared to 2023.
"From 3.8 per cent in 2023, the positivity rate dropped marginally to 3.6 per cent even though significantly more tests were conducted. In 2025 too, over 7,000 tests have already been conducted and our positivity rate so far is just over one per cent. So, the improvement cannot be ignored," the source said in response to a PTI query.
"To be a bit blunt, the athletes and coaches have to rise above their desperation for government jobs which trigger doping violations. Some of the violations are inadvertent, we don't deny that, like taking a medicine which might contain prohibited substances but that's being addressed through apps like 'Know Your Medicine'," he said.
China, which conducted a whopping 24,214 tests in 2024, showed a positivity rate of just 0.2 per cent.
The US anti-doping agency conducted lesser tests than India, 6592 in total, and had a positivity rate of 1.1 per cent.
Russia, which has been ostracised globally for its failure to tackle doping, conducted 10,514 tests and returned a positivity rate of 0.7 per cent with just 76 adverse results in the 2024 figures.
ISL will happen
Another major crisis that has engulfed Indian sports is the pause on the domestic football season after the national federation failed to find a commercial partner following the end of its 10-year deal with Football Sports Development Limited (FSDL).
The ministry has been closely involved in facilitating the negotiations between the All India Football Federation (AIFF) and other stakeholders like the Indian Super League and I-League clubs.
On Friday, the ISL clubs submitted a fresh proposal to the AIFF and the ministry, seeking perpetual operational and commercial rights for a club-owned league model while retaining the national federation as the sport's regulator.
"Proposals will keep coming but be assured, the league will happen. But in this entire fiasco, one must not ignore the fact that the Supreme Court has created a very awkward situation by approving a constitution which may not be acceptable to FIFA as it allows the court to interfere," the source pointed out.
"The AIFF is not free of blame for where football is right now but the court also needs to understand that the federation's autonomy is non-negotiable," he added.
National Sports Awards
The long-awaited National Sports awards will be known soon, according to the ministry.
"The process of scrutiny is on and the awards will be announced soon, in January most likely," he said.